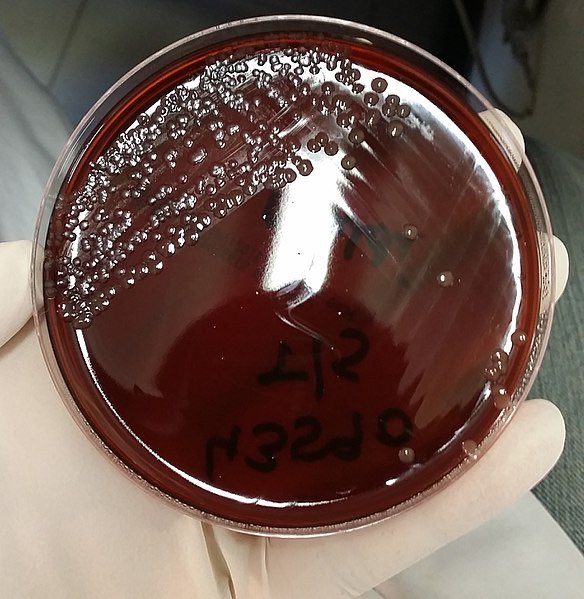

اليوم موضوعنا في #المايكروبيولوجي عن #بكتريا
Neisseria meningitidis
-وهي من G-ve
-تشبه بالCoffee bean حبة القهوة
-لا تتحرك ولها Pili
-تعرف باdiplo cocci
-البكتريا هذه خطيرة و قد تكون مميتة في وقت قصير من دون تدخل طبي
-تسبب meningococcal disease و #التهاب_السحايا
Neisseria meningitidis
-وهي من G-ve
-تشبه بالCoffee bean حبة القهوة
-لا تتحرك ولها Pili
-تعرف باdiplo cocci
-البكتريا هذه خطيرة و قد تكون مميتة في وقت قصير من دون تدخل طبي
-تسبب meningococcal disease و #التهاب_السحايا
-لها كابسولة من polysaccharid
-تمامserogroups مثل A,B,C,D
-و لذلك تصنف على كيميائية الكبسولة
-و بالتالي تنقسم الى serovars استنادا على التنوع في الغشاء الخارجي لل protein antigens
-تنقل بالاتصال المباشر مع المصاب
-تمامserogroups مثل A,B,C,D
-و لذلك تصنف على كيميائية الكبسولة
-و بالتالي تنقسم الى serovars استنادا على التنوع في الغشاء الخارجي لل protein antigens
-تنقل بالاتصال المباشر مع المصاب
الأعراض تشمل
-متنوعة و تعتمد على نوع المرض
-الأعراض الشائعة السخونة المفاجئة الصداع و الأم الرقبة
-الغثيان و الاستفراغ و زيادة الحساسية للإضاء و عدم الإدراك
-الاطفال و الرضع لديهم أعراض أيضا كالاستجابة البطيئة و الخمول
-في بعض الحالات تصل الى العدوى في الدم و الإسهال
-متنوعة و تعتمد على نوع المرض
-الأعراض الشائعة السخونة المفاجئة الصداع و الأم الرقبة
-الغثيان و الاستفراغ و زيادة الحساسية للإضاء و عدم الإدراك
-الاطفال و الرضع لديهم أعراض أيضا كالاستجابة البطيئة و الخمول
-في بعض الحالات تصل الى العدوى في الدم و الإسهال
التشخيص:
بتحديد البكتريا في CSF sample او في الدم
-تزرع مباشرة في blood culture
-اختبار agglutination مطلوب لتحديد serogroup
-في اختبار مباشر بواسطة latex coagulation لتحديد antigen في عينات CSF و للإطلاع
wwwnc.cdc.gov
بتحديد البكتريا في CSF sample او في الدم
-تزرع مباشرة في blood culture
-اختبار agglutination مطلوب لتحديد serogroup
-في اختبار مباشر بواسطة latex coagulation لتحديد antigen في عينات CSF و للإطلاع
wwwnc.cdc.gov
فضلا@Rattibha
جاري تحميل الاقتراحات...